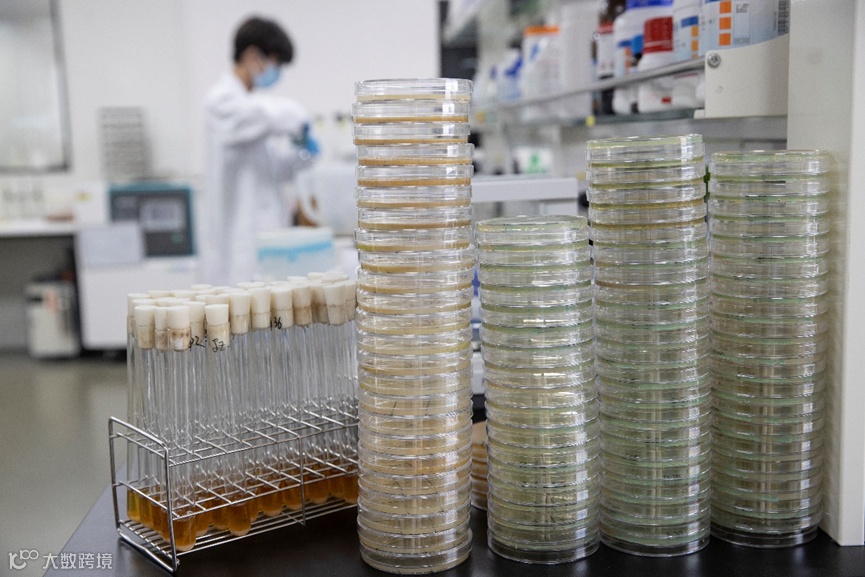

AI制药,浦东企业实力几何?
尽管在全球的AI制药领域还没有一款真正意义上的新药上市,但是浦东AI制药企业凭借过硬的技术实力探索出各具特色的商业化验证道路。
在制药领域,AI让药企仅在数月内就完成了过去需要数年才能实现的结构解析,极大地提升了研发效率。不仅如此,AI还加速了靶标发现和药物设计。过去依赖于大量实验的筛选过程,如今被AI的分子模拟技术大幅简化。尽管如此,新药研发依然需要长时间的巨额投资。而手握AI制药这项技术企业必然要在漫长的马拉松赛道,探索出一条合适的商业化发展之路。
不久前,英矽智能科技(上海)有限公司(以下简称“英矽智能”)研发的一款AI新药在Ⅱa期临床试验中取得了积极的研究结果,这为人工智能驱动的药物研发提供了首次概念性验证。该款药物显示出的安全性和疗效也引起2013年诺贝尔化学奖得主迈克尔·莱维特的注意,并将其视为AI技术为新药研发提供助力的案例。

据了解,药物管线授权是英矽智能目前主要聚焦的业务模式和收入来源,此外AI平台组件授权的订阅费和药物研发合作也为英矽智能贡献了部分收入。英矽智能认为首先要通过自研管线证明自身AI药物研发平台的真正实力。其次是在某些管线推进到临床I期或临床前候选化合物阶段时将其对外授权出去,实现自我造血能力。
2023年9月,英矽智能将旗下由AI研发、已获FDA临床试验批准的小分子药物ISM3091授权给美国上市公司Exelixis,获得8000万美元预付款,后续还根据进度获得阶段性里程碑付款和销售分成。这是亚太区AI制药企业首次实现AI药物的license out。2024年1月,英矽智能再次实现管线对外授权,将候选抗肿瘤药物ISM5043以5亿美元总额对外授权给意大利百年药企美纳里尼。在英矽智能联合首席执行官任峰看来,项目对外授权也是在AI SaaS、AI CRO和AI Biotech之外的“最有前景的商业模式”。
目前英矽智能有30多个自研管线,涵盖29个药物靶点,覆盖纤维化、肿瘤、免疫学等治疗领域,其中有9个项目拿到了临床试验批件,进展最快的项目正在中国和美国同步开展II期临床试验。
AI技术平台获得大型药企的垂青是商业化验证道路上的关键里程碑。浦东另一家AI制药企业晶泰智药技术(上海)有限公司(下称“晶泰科技”)以晶型预测切入制药领域,并与辉瑞签订十年战略合作。此后,该公司逐渐建立起从靶点到临床前候选化合物的AI药物发现能力,建立行业领先的大规模湿实验室,并自主研发、规模化部署了AI机器人实验室。
值得一提的是,结合人工智能、机器人实验等前沿技术的AI机器人创新研发平台,不仅在生物医药多个应用场景落地开花,其溢出效益更扩展到新材料、新能源、精细化工等产业领域。今年6月,晶泰科技与复旦大学化学系麻生明院士团队的合作实现顺利交付,在复旦大学邯郸校区投入使用,已应用于某催化剂合成筛选研究中。今年8月,晶泰科技与协鑫集团签署总金额达10亿人民币的战略合作协议,利用人工智能(AI)与机器人自动化技术,共同推进钙钛矿、超分子、锂离子电池、正极材料、碳硅材料等领域高科技新能源材料创新研发,携手开发一系列具有行业竞争力和工业应用潜力的差异化新材料。
今年6月,晶泰科技在港交所主板成功上市,成为港股18C规则下“特专科技”企业第一股。就在AlphaFold开发者获得诺贝尔化学奖翌日,晶泰科技宣布与美国强生公司下属杨森制药签署大分子药物发现AI平台授权协议,授权其使用与AlphaFold同为蛋白质结构预测算法的XtalFold平台用于生物药研发。
此外,在今年诺贝尔生理学或医学奖授予的miRNA领域,晶泰科技也有布局,例如公司与香港长江生命科技合作开发基于miRNA的癌症预后风险预测分子诊断模型。加之诺贝尔物理学奖的物理+AI方向与晶泰基于量子物理底层技术,结合AI、机器人等前沿技术的方向高度吻合,其技术与服务一次押中三项诺奖。
合成生物学提前布局AI技术平台
文章来源:科Way